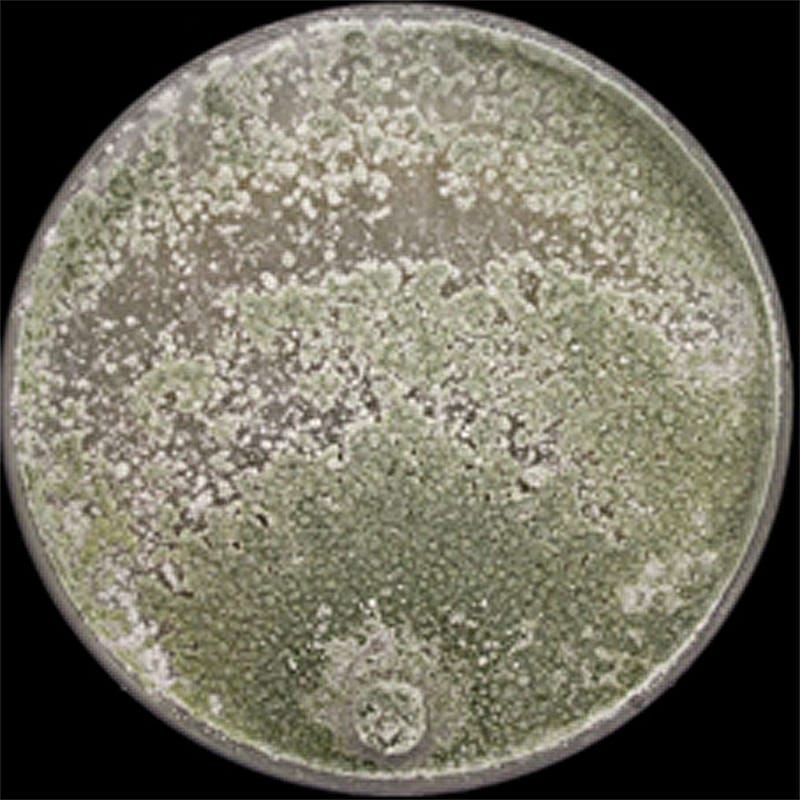

Fungal Biology and Genetics
Research

Hyphal Elongation and Branching
Using the wealth of genetic and cell biology-related tools available for Neurospora crassa (whose hyphae can elongate at up to 4mm per hour), we are dissecting the molecular mechanisms involved in the initiation, maintenance and regulation of polar growth and development in filamentous fungi.

Fungi in the Marine Environment
We are analyzing culturable fungi associated with sessile marine animals (mainly sponges and coral) with the intention of identifying and quantifying their mycobiome constituents. We are also studying the potential contribution of these fungi to coral wellbeing and their ability to produce bioactive products.
Trichoderma Germination and Mycoparasitism
Many members of the genus Trichoderma exhibit mycoparasitic capabilities and are thus candidates for use as environmental-friendly biocontrol agents. We are studying the mechanistic aspects of conidial germination and interaction with host fungi to elucidate the nature of Trichoderma growth and proliferation with the intention of improving its performance in biocontrol.

Wood Decay Fungi
White rot fungi, such as Pleurotus ostreatus, have unique capabilities to degrade lignin and other complex natural and xenobiotic compounds. In close collaboration with Prof. Yitzhak Hadar, we are studying the regulation of lignin degradation in culture and on natural substrates and the interactions between P. ostreatus and other wood-decaying fungi.
Publications
2025
.https://doi.org/10.1093/ismejo/wraf090
2023
- Yarden, O., Zhang, J., Marcus, D., Mabjeesh, S.J., Lipzen, A., Zhang, Y., Savage, E., Ng, V., Grigoriev, I.V. and Hadar, Y. 2023. Altered expression of 2 small secreted proteins (ssp4 and ssp6) affects the degradation of a natural lignocellulosic substrate by Pleurotus ostreatus. Int. J. Mol. Sci. 24, 16828.
- Wang, Z., Kim, W., Wang, Y-W., Yakubovich, L., Dong, C., Trail, F., Townsend, J.P. and Yarden, O. 2023. The Sordariomycetes—an expanding resource with big data for mining evolutionary genomics and transcriptomics Front. Fungal Biol. 4:1214537
- Wang, Z., Wang, Y., Kasuga, T., Lopez-Giraldez, F., Zhang, Y., Zhang, Z., Wang, Y., Dong, C., Sil, A., Trail. F, Yarden, O. and Townsend, J.P. 2023. Lineage-specific genes are clustered with HET-domain genes and respond to environmental and genetic manipulations regulating reproduction in Neurospora. PLoS Genet. 19(11): e1011019
- Crous P.W., Osieck, E.R., Shivas, R.G., Tan, Y.P., Bishop-Hurley, S.L., Esteve-Raventós, F., Larsson, E., Luangsa-ard, J.J., Pancorbo, F., Balashov, S., Baseia IG., Boekhout, T., Chandranayaka, S., Cowan, D.A., Cruz, R.H.S.F., Czachura, P., De la Peña-Lastra, S., Dovana, F., Drury, B., Fell, J., Flakus, A., Fotedar, R., Jurjević, Ž., Kolecka, A., Mack, J., Maggs-Kölling, G., Mahadevakumar, S., Mateos, A., Mongkolsamrit, S., Noisripoom, W., Plaza, M, Overy, D.P., Piątek, M., Sandoval-Denis, M., Vauras, J., Wingfield, M.J., Abell, S.E., Ahmadpour, A., Akulov, A., Alavi, F., Alavi, Z., Altés, A., Alvarado, P., G., N. Ashtekar, N., Assyov, B., Banc-Prandi, G., Barbosa, K.D., Barreto, G.G., Bellanger, J.-M., Bezerra, J.L., Bhat, D.J., Bilański, P., Bose, T., Bozok, F., Chaves, J., Costa-Rezende, D.H., Danteswari, C., Darmostuk, V., Delgado, G., Denman, S., Eichmeier, A., Etayo, J., Eyssartier, G., Faulwetter, S., Ganga, K.G.G., Ghosta, Y., Goh54, J., Góis, J.S., Gramaje, D., Granit, L., Groenewald, M., Gulden, G., Gusmão, L.F.P., Hammerbacher, A., Heidarian, Z., Hywel-Jones, N., Jankowiak, R., Kaliyaperumal, M., Kaygusuz, O., Kezo, K., Khonsanit, A., Kumar, S., Kuo, C.H., Læssøe6, T., Latha, K.P.D., Loizides, M., Luo, S.M., Maciá-Vicente, J.G., Manimohan, P., Marbach, P.A.S., Marinho, P., Marney, T.S., Marques, G., Martín, M.P., Miller, A.N., Mondello, F., Moreno, G., Mufeeda, K.T., Mun, H.Y., Nau, T. Nkomo, T., Okrasińska, A., Oliveira, J.P.A.F., Oliveira, R.L., Ortiz, D.A., Pawłowska, J., Pérez-De-Gregorio, M.À., Podile, A.R., Portugal, A., Privitera, N., Rajeshkumar, K.C., Rauf, I., Rian, B., Rigueiro-Rodríguez, A., Rivas-Torres, G.F., Rodriguez-Flakus, P., Romero-Gordillo, M., Saar, I., Saba, M., Santos, C.D., Sarma, P.V.S.R.N., Siquier, J.L., Sleiman, S., Spetik, M., Sridhar, K.R., Stryjak-Bogacka, M., Szczepańska, K., Taşkın, H., Tennakoon, D.S., Thanakitpipattana, D., Trovão79, J., Türkekul, İ., van Iperen, A.L., van 't Hof, P., Vasquez, G., Visagie, C.M., Wingfield, B.D., Wong, P.T.W., Yang, W.X., Yarar, M., Yarden, O., Yilmaz, N. Zhang, N., Zhu, Y.N. and Groenewald, J.Z. 2023. Fungal Planet description sheets: 1478–1549 Cnidariaphoma eilatica. Persoonia 50: 158–310
-
Wang, Z., Wang, Y., Kasuga, T., Hassler, H., Lopez-Giraldez, F., Dong, C., Yarden, O. and Townsend, J.P. 2023. Origins of lineage-specific elements via gene duplication, relocation, and regional rearrangement in Neurospora crassa. Molec. Ecol
2022
- Gortikov, M., Yakubovich, E., Wang, Z., Lopez-Giraldez, F., Tu, Y., Townsend, J.P. and Yarden, O. 2022. Differential expression of cell wall remodeling genes is part of the dynamic phase-specific transcriptional program of conidial germination of Trichoderma asperelloides. J. Fungi 8(8):854
- Wang, Z., Lopez-Giraldez, F., Slot, J., Yarden, O., Trail, F., and Townsend, J.P. 2022. Secondary metabolism gene clusters exhibit increasingly dynamic and differential expression during asexual growth, conidiation, and sexual development in Neurospora crassa. mSystems 7: e00232-22.
- Crous, P.W., Boers, J., Holdom, D., Osieck, E.R., Steinrucken, T.V., Tan, Y.P., Vitelli, J.S., Shivas, R.G., Barrett, M., Boxshall, A.-G., Broadbridge, J., Larsson, E., T. Lebel, T., Pinruan, U., Sommai, S., Alvarado, P., Bonito, G., Decock, C.A., De la Peña-Lastra, S., Delgado, G., Houbraken, J., Raja, H.A., Rigueiro-Rodríguez, A., Rodríguez, A., Wingfield, M.J., Adams, S.J., Akulov, A., AL-Hidmi, T., Antonín, V., Arauzo, S., Arenas, F., Armada, F., Aylward, J., Bellanger, J.-M., Berraf-Tebbal, A., Bidaud, A., Boccardo, F., Cabero, J., Calledda, F., G. Corriol, G., Crane, J.L., Dearnaley, J.D.W., Dima, B., Dovana, F., Eichmeier, A., Esteve-Raventós, F., Fine, M., Ganzert, L., García, D., Garcia, D.T., Gené, J., Gutiérrez, A., Iglesias, P., Istel, L., Izquierdo, A.M., Jangsantear, P., Jansen, G.M., Jeppson, M., Karun, N.C., Karich, A., Khamsuntorn, P., Kokkonen, K., Kolařík, M., Kubátová, A., Labuda, R., Lagashetti, A.C., Lifshitz, N., Linde, C., Loizides, M., Luangsa-ard, J.J., Lueangroenkit, P., Maciá-Vicente, J.G., Mahadevakumar, S., Mahamedi, A.E., Malloch, D.W., Marincowitz, S., Mateos, A., Moreau, P.-A., Miller, A.N., Molia, A., Morte, A., Navarro-Ródenas, A., Nebesářová, J., Nigrone, E., Nuthan, B.R., Oberlies, N.H., Pepori, A.L., Rämä, T., Rapley, D., Reschke, K., Robicheau, B.M., Roets, F., Roux, J., Saavedra, M., Sakolrak, B., Santini, A., Ševčíková, H., Singh, P.N., Singh, S.K., Somrithipol, S., Spetik, M., Sridhar, K.R., Starink-Willemse, M., Taylor, V.A., van Iperen, A.L., Vauras, J., Walker, A.K., Wingfield, B.D., Yarden, O. and Groenewald, J.Z. 2022. Fungal planet description sheets: 1383–1435. 1418 Microascus rothbergiorum. Persoonia 48: 261– 371.
- Gortikov, M., Wang, Z., Steindorff, A.S., Grigoriev, I.V., Druzhinina, I.S., Townsend, J.P. and Yarden, O. 2022. Sequencing and analysis of the entire genome of the mycoparasitic bioeffector fungus Trichoderma asperelloides strain T 203 (Hypocreales). Microbiol. Resour. Announc. 11 :e00995-21.
- Nomberg, G., Marinov, O., Karavani, E., Manasherova, E., Zelinger, E., Yarden, O. and Cohen, H. 2022. Cucumber fruit skin reticulation affects post-harvest traits. Postharvest Biology and Technology 194, 112071.
2021
- Herold, I, Zolti, A., Garduno-Rosales, M., Wang, Z., Lopez-Giraldez, F., Murino-Perez, R.R., Townsend, J.P., Ulitsky, I. and Yarden, O. 2021. The GUL-1 protein binds multiple RNAs involved in cell wall remodeling and affects the MAK-1 pathway in Neurospora crassa. Front. Fungal Biol. 2:672696.
- Ben Dor Cohen, E., Ilan, M. and Yarden, O. 2021. The culturable mycobiome of mesophotic Agelas oroides: constituents and changes following sponge transplantation to shallow water. J. Fungi 7(7): 567.
2020
- Lifshitz, N., Hazanov, L., Fine, M. and Yarden, O. 2020. Seasonal variations in the culturable mycobiome of Acropora loripes along a depth gradient. Microorganisms 8, 1139;
- Feldman, D., Yarden, O. and Hadar, Y. 2020. Seeking the roles for fungal small-secreted proteins in affecting saprophytic lifestyles. Front. Microbiol. 11:455
- Hou, L.W., Groenewald, J.Z., Pfenning, L.H., Yarden, O., Crous, P.W. and Cai, L. 2020. The phoma-like dilemma. Stud. Mycol.
- Meyer, V., Evelina Y. Basenko, E.Y., Benz, JP, Braus, G.H., Caddick, M.X, Csukai, M., de Vries, R.P., Endy, D., Frisvad, J.C., Gunde-Cimerman, N., Haarmann, T., Hadar, Y., Hansen, K., Johnson, R.I., Keller, N.P., Kraševec, N., Mortensen, U.H., Perez, R., Ram, A.F.J., Record, E., Ross, P., Shapaval, V., Steiniger, C., van den Brink, H., van Munster, J., Yarden, O. and Wösten, H.A.B. 2020. Growing a circular economy with fungal biotechnology: A white paper. Fung. Biol. Biotech. 7, 5.
- Alder-Rangel, A., Idnurm, A., Brand, A.C., Brown, A.J.P., Gorbushina, A.,Kelliher, C.M., Campos, C.B., Levin, D.E., Bell-Pedersen, D., Dadachova, E., Bauer, F.F., Gadd, G.M.,Braus, G.H., Braga, G.U.L., Brancini, G.T.P., Walker, G.M., Druzhinina, I., Pócsi, I., Dijksterhuis, J.,Aguirre, J., Hallsworth, J.E., Schumacher, J., Wong, K.H., Selbmann, L., Corrochano, L.M., Kupiec, M.,Momany, M., Molin, M., Requena, N., Yarden, O., Cordero, R.J.B., Fischer, R., Pascon, R.C., Mancinelli,R.L., Emri, T., Basso, T.O., Rangel, D.E.N. 2020. The Third International Symposium on Fungal Stress –ISFUS. Fung. Biol. 124: 235-252.
2019
- Feldman, D., Kowbel, D.J., Cohen, A., Glass, N.L., Hadar, Y. and Yarden, O. 2019. Identification and manipulation of Neurospora crassa genes involved in sensitivity to furfural. Biotech. Biofuels 12:210.
- Feldman, D., Amedi, N., Carmeli, S., Yarden, O. and Hadar, Y. 2019. Small secreted proteins (SSPs) act as a checkpoint for fungal development and metabolism in the white-rot fungus Pleurotus ostreatus. Appl. Environ. Microbiol. 85 (15): e00761-19.
- Herold, I., Kowbel, D., Delgado-Álvarez, D., Garduño-Rosales, M., Mouriño-Pérez, R.R. and Yarden, O. 2019. Transcriptional profiling and localization of GUL-1, a COT-1 pathway component, in Neurospora crassa. Fung. Genet. Biol. 126:1-11
- Wang, Z., Miguel-Rojas, C., Lopez-Giraldez, F., Yarden, O., Trail, F. and Townsend, J. 2019. Metabolism and development during conidial germination in response to a carbon-nitrogen-rich synthetic or a natural source of nutrition in Neurospora crassa. mBio 10:e00192-19.
- Amend, A., Burgaud, G., Cunliffe, M., Edgcomb, V.P., Ettinger, C., Gutiérrez, M.H., Heitman, J., Hom, E.F.Y., Ianiri, G., Jones, A.C., Kagami, M., Picard, K.T., Quandt, C.A., Raghukumar, S., Riquelme, M., Stajich, J., Vargas-Muñiz, J., Walker, A.K., Yarden, O. and Gladfelter, A.S. 2019. Fungi in the marine environment: open questions and unsolved problems. mBio 10:e01189-18.
2018
- Aharoni-Kats, L., Zelinger, E., Chen, S. and Yarden, O. 2018 Altering Neurospora crassa MOB2A exposes its functions in development and affects its interaction with the NDR kinase COT1. Mol. Microbiol. 108: 641–660 (featured on the cover)
- du Plessis, I.L., Druzhinina, I.S., Atanasova, L., Yarden, O. and Jacobs, K. 2018. The diversity of Trichoderma species from soil in South Africa with five new additions. Mycologia 110:559-583 (featured on the cover)
- Yoav, S., Salame, T.M., Feldman, D., Levinson, D., Ioelovich, M., Morag, E., Yarden, O., Bayer, E.S. and Hadar, Y. 2018. Effects of cre1 modification in the white-rot fungus Pleurotus ostreatus PC9: Altering substrate preference during biological pretreatment. Biotech. 11:212
2017
- Shomin-Levi, H. and Yarden, O. 2017. The Neurospora crassa PP2A regulatory subunits RGB1 and B56 are required for proper growth and development and interact with the NDR kinase COT1. Front. Microbiol. 8:1694. doi: 10.3389/fmicb.2017.01694
- Herold, I. and Yarden, O. 2017. Regulation of Neurospora crassa cell wall remodeling via the cot-1 pathway is mediated by gul-1. Curr. Genet. 63:145-159.
- Nimri, L., Spivak, O., Tal, D., Schälling, D., Peri, I., Graeve, L., Salame, T.M., Yarden, O., Hadar, Y. and Schwartz, B. 2017. A recombinant fungal compound induces anti-proliferative and pro-apoptotic effects on colon cancer cells. Oncotarget 8:28854-28864.
- Simkovitch, R., Gajst, O., Zelinger, E, Yarden, O. and Huppert, D. 2017. Irradiation by blue light in the presence of a photoacid confers changes to colony morphology of the plant pathogen Colletotrichum gloeosporioides. Photochem. Photobiol. B: Biol. 174:1-9.
2016
- Yarden, O. 2016. Model fungi: engines of scientific insight. Fung. Biol. Rev. 30:33-35.
- Knop, D., Levinson, D., Makovitzki, A., Agami, A., Lere, E., Mimram, A., Yarden, O., and Hadar, Y. 2016. Limits of versatility of versatile peroxidase. Appl. Environ. Microbiol. 82:4070-4080.
- Lang-Yona, N., Shuster-Meiseles, T., Mazar, Y., Yarden, O. and Rudich, Y. 2016. Impact of urban air pollution on the allergenicity of Aspergillus fumigatus conidia: Field sampling supported by laboratory experiments. Sci. Total Environ. 541:365-371.
2015
- López-Legentil, S., Erwin, P.M., Turon, M. and Yarden, O. 2015. Diversity of fungi isolated from three temperate ascidians. Symbiosis 66:99-106.
- Cohen, R., Orgil, G., Burger, Y., Saar, U., Elkabetz, M., Tadmor, Y., Edelstien, M., Belausov, E., Maymon, M., Freeman, S. and Yarden, O. 2014. Differences in the responses of melon accessions to Fusarium crown rot and their colonization by Fusarium oxysporum f. sp. radicis cucumerinum. Plant Pathology 64:655-663
- Knop, D., Yarden, O. and Hadar, Y. 2015. The ligninolytic peroxidases in the genus Pleurotus: Divergence in activities, expression and potential applications. Appl. Microbiol. Biotechnol. 99:1025-1038.
- Kabbage, M., Yarden, O. and Dickman, M.B. 2015. Dining habits of Sclerotinia sclerotiorum: switching from biotrophic to necrotrophic lifestyle. Plant Sci. 233:53–60.
2014
- Koch, L., Lodin, A., Herold, I., Ilan, M. Carmeli, S. and Yarden, O. 2014. Sensitivity of Neurospora crassa to a marine-derived Aspergillus tubingensis anhydride exhibiting antifungal activity that is mediated by the MAS1 protein. Mar. Drugs 12:4713-4731
- Yarden, O., Veluchamy, S., Dickman, M.B. and Kabbage, M. 2014. Sclerotinia sclerotiorum catalase SCAT1 increases tolerance to oxidative stress, regulates ergosterol levels and controls pathogenic development. Physiol. Mol. Plant Pathol. 85:34-41
- Salame, T.M., Knop, D., Levinson, D., Mabjeesh, S.J., Yarden, O. and Hadar, Y. 2014. Inactivation of a Pleurotus ostreatus versatile-peroxidase-encoding gene (mnp2) results in reduced lignin degradation. Environ. Microbiol. 16: 265–277
- Knop, D., Ben-Ari, J., Salame, T.M., Levinson, D., Yarden, O. and Hadar, Y. 2014. Mn2+-deficiency reveals a key role for the Pleurotus ostreatus versatile MnP (VP4) in oxidation of aromatic compounds. Appl. Microbiol. Biotechnol. 98:6795–6804.
2013
- Ziv, C., Feldman, D., Aharoni-Kats, L., Chen, S., Liu, Y. and Yarden, O. 2013. The N-terminal region of the Neurospora NDR kinase COT1 regulates morphology via its interactions with MOB2A/B. Mol. Microbiol. 90:383-399
- Feldman, D., Ziv, C., Gorovits, R., Efrat, M. and Yarden, O. 2013. Neurospora crassa protein arginine methyl transferases are involved in growth and development and interact with the NDR kinase COT1. PLoS One
- Lang-Yona, N., Levin, Y., Dannemiller, K., Yarden, O., Peccia, J. and Rudich, Y. 2013. Changes in atmospheric CO2 influence the allergenicity of Aspergillus fumigatus. Glob. Chang. Biol. 19: 2381–2388.
- Salame, T.M., Knop, D., Levinson, D., Yarden, O. and Hadar, Y. 2013. Redundancy amongst manganese-peroxidases in Pleurotus ostreatus. Appl. Environ. Microbiol. 79: 2405–2415
- Panizel, I., Yarden, O., Ilan, M and Carmeli, S. 2013. Eight novel peptaibols from sponge-associated Trichoderma atroviride. Mar. Drugs 11:4937-4960.
2012
- Salame, T., Knop, D., Tal, D., Levinson, D., Yarden, O. and Hadar, Y. 2012. A gene-targeting system for Pleurotus ostreatus: Demonstrating the predominance of versatile-peroxidase (mnp4) by gene replacement.
- Salame, T., Knop, D., Tal, D., Levinson, D., Mabjeesh, S.J., Yarden, O. and Hadar, Y. 2012. Release of Pleurotus ostreatus versatile-peroxidase from Mn2+ repression enhances anthropogenic and natural substrate degradation.
- Ferandez-Fueyo, E., Ruiz-Duenas, F., Ferreira, P., Floudas, D., Hibbett, D., Canessa, P., Larrondo, L., James, T., Seelenfreund, D., Lobos, S., Polanco, R., Tello, M., Honda, Y., Watanabe, T., Jae San, R., Kubicek, C., Schmoll, M., Gaskell, J., Hammel, K., St. John, F., Vanden Wymelenberg, A., Sabat, G., Splinter BonDurant, S., Syed, K., Yadav, J., Doddapaneni, H., Subramanian, V., Laven, J., Oguiza, J., Perez, G., Pisabarro, A., Ramirez, L., Santoyo, F., Master, E., Coutinho, P., Henrissat, B., Lombard, V., Magnuson, J., Kues, U., Hori, C., Igarashi, K., Samejima, M., Held, B., Barry, K., LaButti, K., Lapidus, A., Lindquist, E., Lucas, S., Riley, R., Salamov, A., Hoffmeister, D., Schwenk, D., Hadar, Y., Yarden, O., de Vries, R., Wiebenga, A., Stenlid, J., Eastwood, D., Grigoriev, I., Berka, R., Blanchette, R., Kersten, P., Martinez, A., Vicuna, R., and Cullen, D. 2012.Comparative genomics of Ceriporiopsis subvermispora and Phanerochaete chrysosporium provide insight into selective ligninolysis.
- Lang-Yona, N., Dannemiller, K., Yamamoto, N., Peccia, J., Yarden, O., Burshtein, N. and Rudich, Y. 2012. Annual distribution of allergenic fungal spores in atmospheric particulate matter in the eastern Mediterranean; A comparative study between ergosterol and quantitative PCR analysis.
2011
- Kapri-Pardes, E., Haviv, H., Mahmoud, Y., Ilan, M., Khalfin-Penigel, I., Carmeli, S., Yarden, O. and Karlish, S.J.D. 2011. Stabilization of the α2 isoform of Na,K-ATPase by mutations in a phospholipid binding pocket. J. Biol. Chem. 286:42888-42899 abstract
- Bardea, A., Burshtein, N., Rudich, Y., Salame, T., Ziv, C., Yarden, O. and Naaman, R. Sensitive detection and identification of DNA and RNA using a patterned capillary tube (PCT). Anal. Chem. 83:9418-9423
- Amselem, J., Cuomo, C.A. , van Kan, J.A.L., Viaud, M., Benito, E.P., Couloux, A., Coutinho, P.M., de Vries, R.P., Dyer, P.S., Fillinger, S., Fournier, E., Gout, L., Hahn, M., Kohn, L., Lapalu, N., Plummer, K.M., Pradier, J.-M., Quévillon, E., Sharon, A., Simon, A., ten Have, A., Tudzynski, B., Tudzynski, P., Wincker, P., Andrew, M., Anthouard, V., Beffa, R., Benoit, I., Bouzid, O., Chen, Z., Choquer, M., Collémare, J., Cotton, P., Danchin, E.G., Da Silva, C., Gautier, A., Giraud, C., Giraud, T., Gonzalez, C., Grossetete, S., Güldener, U., Henrissat, B., Howlett, B., Kodira, C., Kretschmer, M., Lappartient, A., Leroch, M., Levis, C., Mauceli, E., Neuvéglise, C., Oeser, B., Pearson, M., Poulain, J., Poussereau, N., Quesneville, H., Rascle, C., Schumacher, J., Ségurens, B., Sexton, A., Silva, E., Sirven, C., Soanes, D.M., Talbot, N.J., Yandava, C., Yarden, O., Zeng, Q., Rollins, J.A., Lebrun, M.-H., Dickman, M.B. 2011. Genomic analysis of the necrotrophic fungal pathogens Sclerotinia sclerotiorum and Botrytis cinerea. PLOS Genetics 7: e1002230.
- Denisov, Y. Yarden, O. and Freeman, S. 2011. The transcription factor SNT2 is involved in fungal respiration and reactive oxidative stress in Fusarium oxysporum and Neurospora crassa.
- Gal-Hemed, I., Atanasova, L., Komon-Zelazowska, M., Druzhinina, I.S., Viterbo, A. and Yarden, O. 2011. Marine isolates of Trichoderma as potential halotolerant agents of biological control for arid-zone agriculture. Appl. Environ. Microbiol. 77:5100-5109
- Cohen, E., Koch, L., Myint Thu, K., Rahamim, Y., Aluma, Y., Ilan, M., Yarden, O. and Carmeli, S. 2011. Novel terpenoids of the fungus Aspergillus insuetus isolated from the Mediterranean sponge Psammocinia sp. collected along the coast of Israel. Bioorg. Med. Chem. 19:6587-6593 doi:10.1016/j.bmc.2011.05.0450
- Costantino, V., Mangoni, A., Teta, R., Kra-Oz, G. and Yarden, O. 2011. Neurosporaside, a tetraglycosylated sphingolipid from Neurospora crassa.
- Riquelme, M., Yarden, O., Bartinicki-Garcia, S., Bowman, B., Castro-Longoria, E., Free, S., Felissner, A., Freitag, M., Lew, R.R., Mourino-Perez, R., Plamann, M., Rasmussen, C., Richthammerj, C., Roberson, R.W., Sanchez-Leon, E., Seiler, S. and Waters, M.K., 2011. Architecture and development of the Neurospora crassa hypha - a model cell for polarized growth. Fung.
- Salame, T.M., Ziv, C., Hadar, Y. and Yarden, O. 2011. RNAi as a potential tool for biotechnological applications. Appl. Microbiol. Biotech. 89:501-512 abstract.
- Denisov, Y., Freeman, S. and Yarden, O. 2011. Inactivation of Snt2, a BAH/PHD-containing transcription factor, impairs pathogenicity and increases autophagosome abundance in Fusarium oxysporum. Mol. Plant Pathol. 12:449-461 abstract
2010
- Osherov, N. and Yarden, O. 2010. The fungal cell wall. Pages 224-237 in: Borkovich, K.A. and Ebbole, D.J. (eds). Cellular and Molecular Biology of Filamentous Fungi. American Society of Microbiology Press.
- Ziv, C. and Yarden, O. 2010. Gene silencing for functional analysis: Assessing RNAi as a tool for manipulation of gene expression. Pages 77-100 in: Sharon, A. (ed) Molecular Biology Methods for Fungi. Humana Press.
- Paz, Z., Komon-Zelazowska, M., Druzhinina, I.S., Aveskamp, M.M., Schnaiderman, A. Aluma, A., Carmeli, S., Ilan, M. and Yarden, O. 2010. Diversity and potential antifungal properties of fungi associated with a Mediterranean sponge. Fung. Divers. 42:17-26 article
- Dvash, E. Kra-Oz, G. Ziv, C. Carmeli, S. and Yarden, O. 2010. The NDR kinase DBF-2 is involved in regulation of mitosis, conidial development and glycogen metabolism in Neurospora crassa. Eukaryot. Cell 9:502-513 pubmed
- Salame, T.H., Yarden, O. and Hadar, Y. 2010. Pleurotus ostreatus manganese-dependent peroxidase silencing impairs decolorization of Orange II. Microb. Biotech. 3:93-106ש
People
alumni
Former students have found positions in academia and research institutes, in BioTech, FoodTech and MedTech industries, and at the Ministry of Health.
|
|
טקסט לדוגמא
טקסט לדוגמא
Contact
- הפקולטה לחקלאות רחובות
- Department of Plant Pathology and Microbiology The Robert H. Smith Faculty of Agriculture, Food & Environment The Hebrew University of Jerusalem Herzl 229 Rehovot 7610001 ISRAEL























































